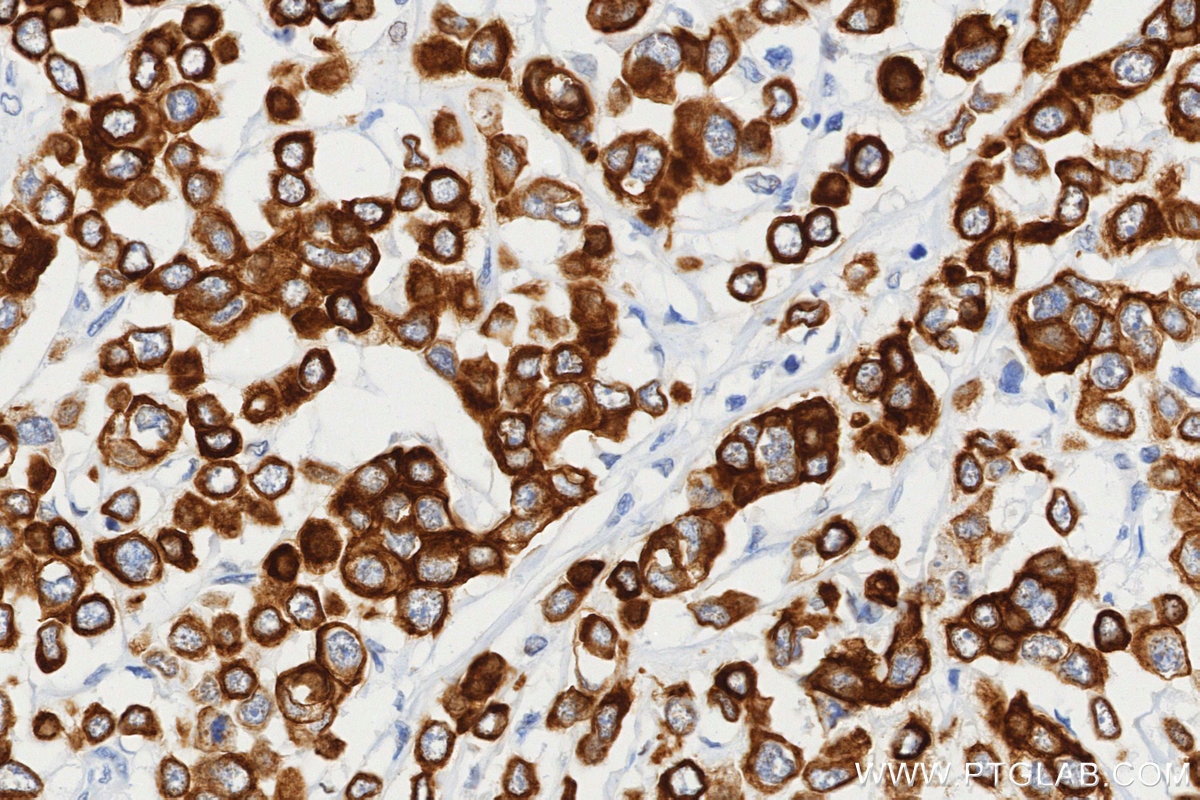
Immunohistochemistry (IHC) staining of human breast cancer tissue using TRAIP Recombinant monoclonal antibody (86808-1-RR)

Product Information
86808-1-PBS targets TRAIP in WB, IHC, Indirect ELISA applications and shows reactivity with human samples.
| Tested Reactivity | human |
| Host / Isotype | Rabbit / IgG |
| Class | Recombinant |
| Type | Antibody |
| Immunogen |
CatNo: Ag0491 Product name: Recombinant human TRAIP protein Source: e coli.-derived, PGEX-4T Tag: GST Domain: 1-204 aa of BC000310 Sequence: MPIRALCTICSDFFDHSRDVAAIHCGHTFHLQCLIQWFETAPSRTCPQCRIQVGKRTIINKLFFDLAQEEENVLDAEFLKNELDNVRAQLSQKDKEKRDSQVIIDTLRDTLEERNATVVSLQQALGKAEMLCSTLKKQMKYLEQQQDETKQAQEEARRLRSKMKTMEQIELLLQSQRPEVEEMIRDMGVGQSAVEQLAVYCVSL Predict reactive species |
| Full Name | TRAF interacting protein |
| Calculated Molecular Weight | 53 kDa |
| Observed Molecular Weight | 53 kDa |
| GenBank Accession Number | BC000310 |
| Gene Symbol | TRAIP |
| Gene ID (NCBI) | 10293 |
| Conjugate | Unconjugated |
| Form | Liquid |
| Purification Method | Protein A purification |
| UNIPROT ID | Q9BWF2 |
| Storage Buffer | PBS only, pH 7.3. |
| Storage Conditions | Store at -80°C. |
Background Information
E3 ubiquitin-protein ligase TRAIP (TRAIP) is also named RING finger protein 206 (RNF206) and TRAF-interacting protein (TRIP). TRAIP, an E3 ligase containing a RING domain, has emerged as a significant contributor to maintaining genome integrity and TRAIP inhibits proliferation and migration of BLCA cells (PMID: 38123820). TRAIP helps replisomes overcome DNA interstrand crosslinks and DNA-protein crosslinks, whereas in mitosis it triggers disassembly of all replisomes that remain on chromatin (PMID: 33317933, PMID: 30842657).